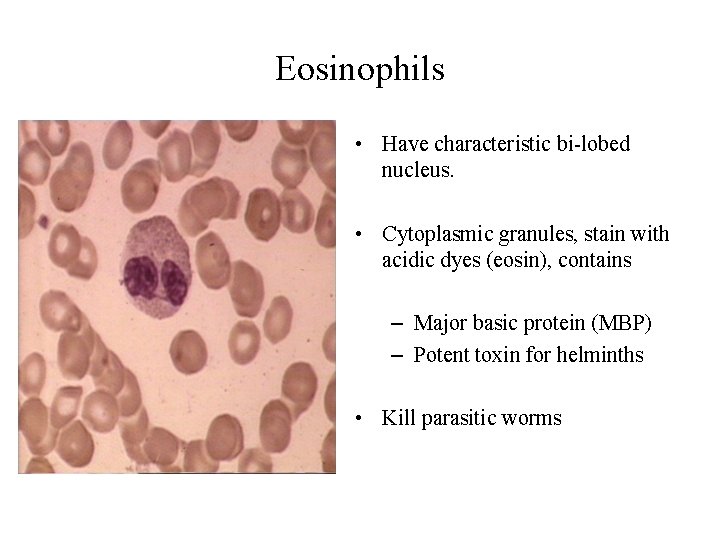
Eosinophils • Have characteristic bi-lobed nucleus. • Cytoplasmic granules, stain with acidic dyes (eosin),

Cells of Immune system Department of Microbiology Immune

Cells of Immune system Department of Microbiology



Immune system Myeloid cells Lymphoid cells Granulocytic Monocytic T cells B cells Neutrophils Basophils Macrophages Kupffer cells Helper cells Suppressor cells Plasma cells Eosinophils Dendritic cells Cytotoxic cells NK cells

Bacteria Viruses Fungi Parasites, etc Pathogens Immune response Adaptive immunity Humoral B lymphocytes antibodies Cellular T lymphocytes CD 4+ CD 8+ Regulatory T cells Pathogen elimination Innate immunity Neutrophils Monocytes/Macrophages Dendritic cells Natural killer cells Interferons Interleukins Cytokines Chemokines Reactive oxygen substances

Cells of Innate Immune System • Phagocytes – PMNs/neutrophils – Monocytes/macrophages • • NK cells Basophils and mast cells Eosinophils Platelets

Neutrophils • Most abundant type of white blood corpuscles in mammals. • Characteristic polymorphic nucleus and cytoplasm • Neutrophils are phagocytic cells. • During the beginning (acute) phase of inflammation, particularly as a result of bacterial infection, neutrophils are one of the first to migrate towards the site of inflammation. • Thus, forms first line of defense.

Macrophages • Literally, “large eaters. ” • These are large, long-lived phagocytes which capture foreign cells, digest them, and present / manifest protein fragments (peptides) on their exterior. • In this manner, they present the antigens to the T cells. • Macrophages are strategically located in lymphoid tissues, connective tissues and body cavities, where they are likely to encounter antigens. • They also act as effector cells in cellmediated immunity.

• • • Alveolar macrophages Histiocytes Kupffer cells Mesangial cells Microglial cells Osteoclasts : lung : connective tissues : liver : kidney : brain : bone


NK cells • T lymphocytes which do not have/ bear either CD 4 or CD 8 markers are called NK cells. • Also known as large granular lymphocytes (LGL). • Kill virus-infected or transformed cells. • Identified by the CD 56+/CD 16+/CD 3 • Activated by IL-2 and IFN-γ to become lymphokine activated killer (LAK) cells.
Eosinophils • Have characteristic bi-lobed nucleus. • Cytoplasmic granules, stain with acidic dyes (eosin), contains – Major basic protein (MBP) – Potent toxin for helminths • Kill parasitic worms

Mast Cell • Large number of mast cells are present within the respiratory and gastrointestinal tracts, and within the deep layers of the skin. • These cells release histamine upon encountering certain antigens, thereby triggering an allergic reaction. • Role in immunity against parasites

Process of Phagocytosis


Cells of Adaptive Immune Response

Cells of adaptive immune response • Lymphocytes – B cells • Plasma cells (Ab producing) • B-memory Cells – T cells • Cytotoxic (CTL) • Helper (Th) – Th 1 – Th 2

Lymphocytes • Mature lymphocytes are small cells with a large nucleus and scanty cytoplasm. • There are two broad sub-types of lymphocyte known as B cells and T cells. • All of them are derived from the bone marrow. • In most of the mammals, B cells mature in Bone marrow itself whereas T cells undergo a process of maturation in the thymus. • B and T cells circulate in the blood and through body tissues.

Lymphocyte Classes

Lymphocytes • B cells give rise to PLASMA CELLS which secrete immunoglobulins (antibodies). Thus, responsible for humoral immunity. • T cells take part in cell mediated immunity. • However, a sub-population of T cells called T helper cells (CD 4+) cells secrete cytokines and thereby help in both cellular and humoral immune responses. • CD 8+ T cells are cytotoxic cells and main mediator of cell mediated immune response (CMI). • CD 8+ cells are able to cause lysis of infected cells.

B-Cells • B cells are produced in bone marrow. • In most of the mammals, they also mature and acquire immune competence in Bone marrow itself. • In mammals like ruminants, B cells mature in Peyer’s patches and in birds they mature in “Bursa of Fabricius” (Hence the name “B cells). • A mature B cells bear Ig. M and Ig. D antibodies on their surface which act as B cell receptors (BCRs). • All the antibody molecule present on the surface of B cells have single specificity i. e. , specificity for any single epitope. • Upon maturity, B cells keep on circulating throughout the blood and lymph looking for antigens.

B-Cells • Once a B cell has identified an antigen / epiotope, it starts replicating (Clonal selection theory). • The B cells produced in response to antigen stimulation will finally differentiates into two types: a) Plasma Cells b) Memory Cells • Plasma cells: Specialized B cells which produce antibodies—more than two thousand per second. • Memory cells: Some of the B cells differentiates into Memory cells are long-lived cells which are capable of mounting immediate response when they encounter same antigen again.

– Antigen exposure activates only T and B cells with receptors that recognize specific epitopes on that antigen – B and T cell clones contain lymphocytes that develop into: • Effector cells that which target pathogens • Memory cells are long-lived B and T cells – They are capable of division on short notice 23

B lymphocytes Make Antibodies and Memory B cells

T-cells • Unlike B cells, these cells leave the marrow at an early age and travel to the thymus, where they mature. • During maturation T cells acquire T- cell receptors in thymus. • The acquisition / generation of T cell receptors is a random phenomenon. Thus, these T cells receptors can recognize all sorts of antigen molecules. • Here in thymus, T cells binding to the “self antigens” undergo “Negative selection” and eventually die. • Thus, only those T cells that do not bind to self antigens are released in the circulation. This forms the basis of self –non self recognition.

T-cells • T cells have two important sub populations called helper T cells (CD 4+) and cytotoxic (or killer) T cells (CD 8+). • These cells travel through the blood and lymph, looking for antigens (such as those captured by antigen-presenting cells). • It is interesting to note that T cells can recognize any antigen / epitope only when they are presented in association with “MHC molecule. ” • T helper cells: These CD 4 + cells secretes cytokines which help both B and T cells to mount humoral and cellular immune response, respectively. T helper cells recognize antigen only in association with MHC II molecule. • T cytotoxic cells: These CD 8+ cells kill the cells exhibiting non self antigen on their surfaces in association with MHC I molecule.


Antigen Presenting Cells • Cells that link the innate and adaptive arms – Antigen presenting cells (APCs) • Macrophages, Dendritic cells and B cells are considered as professional antigen presenting cells. • They expression MHC class II molecules. • In association with MHC II molecules APCs present antigenic peptides to T helper cells (CD 4+ cells). • T helper cells help in mounting both cell mediated and humoral immune response by adaptive arm.

Adaptive immunity Antigen presentation and T cell activation Th 1 CD 8+ MHC Class II CD 80, CD 86 MHC Class I Microbes Viral products Cytokines Etc. IFNg IL- 2 Naïve Th 0 CD 4+ APC Monocytes Dendritic cells T cells Co-stimulatory signals Th 2 IL-12, IL-18, IL-6, IL-8, TNF-a, IL-10 IL- 4

Adaptive immunity Antigen presentation and T cell activation IL-12, IL-10 APC MHC Class II CD 80, CD 86 Naïve Th 0 Th 1 Antigen-specific T cell proliferation CD 4+ Co-stimulatory signals Microbes Viral products Cytokines Etc. APC MHC Class II CD 80, CD 86 Naïve Th 0 CD 4+ Co-stimulatory signals Low IL-12, High IL-10 Th 2 T cell anergy

CD 8 Expansion

Circulation of Immune cells • Every B and T cells have predetermined specificity. • For mounting immune response, specific B or T cell must come in contact with antigen molecule. • To make it possible cells of immune system keep on circulating through blood and lymph. • Mostly antigen inoculated through IV route is trapped in Spleen while through IM/SC routes are trapped in regional lymph nodes.

THANKS

Important Markers on lymphocytes Marker B cell T-cytotoxic cells T-helper Antigen R BCR (surface Ig) TCR CD 3 -- + + CD 4 -- -- + CD 8 -- + -- CD 19/ CD 20 + -- -- CD 40 + -- --

Bone Marrow Tissues Thymus Stem cell Granulocyte T cell Myeloid progenitor Lymphoid progenitor NK cell Mast cell B cell Monocyte 2° Lymphoid Macrophage Dendritic cell Plasma Cell
- Slides: 35